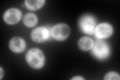
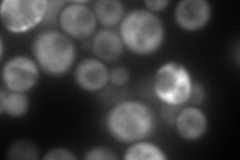
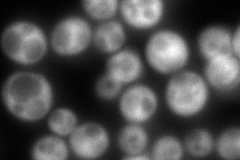

View description
Elongation factor 2 (EF-2), also encoded by EFT2; catalyzes ribosomal translocation during protein synthesis; contains diphthamide, the unique posttranslationally modified histidine residue specifically ADP-ribosylated by diphtheria toxin
Localization:
Intensity:
Fold change:
Significance:
-
C’ GFP library in SD
cytosol502.3 -
N' NOP1pr-GFP in SD

cytosol566.445 -
N' TEF2pr-mCherry in SD
cytosol313.328 -
N' NATIVEpr-GFP in SD
cytosol224.499 -
N' TEF2pr-VC and Cyto-VN in SD

cytosol71.8296 -
C’ GFP library in SD+DTT

cytosol338.660.67No -
C’ GFP library in SD+H2O2

cytosol392.190.78No -
C’ GFP library in Starvation Media

cytosol29.690.05No -
C’ GFP library on the background of Pup2-DaMP

cytosol -
C’ GFP library on the background of CCT mutant

cytosol403.2520.802805No
